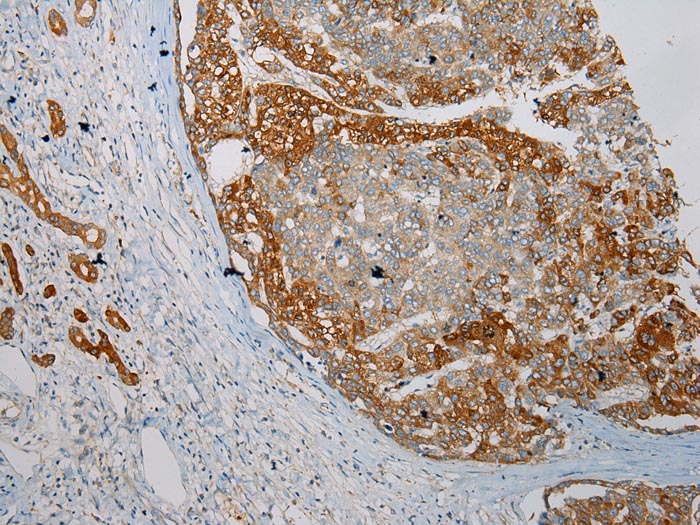

IFI16 Antibody
CAB14002
TargetHGD
Product group Antibodies
Overview
- SupplierAssay Genie
- Product NameIFI16 Rabbit pAb
- Delivery Days Customer9
- Applications SupplierWB,IHC
- CertificationResearch Use Only
- ClonalityMonoclonal
- Gene ID3081
- Target nameHGD
- Target descriptionhomogentisate 1,2-dioxygenase
- Target synonymsAKU; HGO; homogentisate 1,2-dioxygenase; homogentisate oxidase; homogentisate oxygenase; homogentisic acid oxidase; homogentisicase
- HostRabbit
- Protein IDQ93099
- Protein NameHomogentisate 1,2-dioxygenase
- Shelf life instruction12 months
- SourceRabbit
- Reactivity SupplierHuman,Mouse,Rat
- Storage Instruction-20°C
- UNSPSC12352203